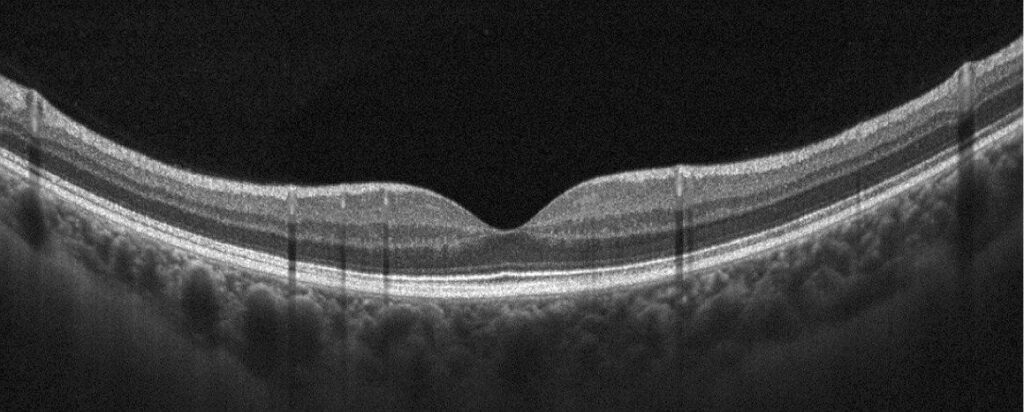
Exame normal de OCT da região da mácula

A tomografia de coerência óptica, também chamada de OCT, é um exame que utiliza luz para avaliar as camadas da retina. É um dos exames mais modernos e úteis da oftalmologia e permite avaliar as células da retina e identificar uma série de doenças como edema de mácula, coroidopatia serosa central, burado de mácula e degeneração macular relacionada à idade, entre outras. Também pode ser útil em casos de uveítes, tumores intra oculares, fosseta de papila, etc.
O exame de OCT permite o diagnóstico e também o acompanhamento de todas estas doenças. Não existe nenhum risco no exame de OCT e apesar do nome não utiliza nenhum tipo de radiação, apenas luz.
Existem diferentes aparelhos de OCT, que apresentam variadas velocidades e definições de imagem. Os aparelhos mais modernos possuem a tecnologia “spectral domain OCT” ou “swept source OCT”, fornecendo imagens de altíssima resolução adquiridas em um curto tempo de exame. Além disso, alguns aparelhos também oferecem a modalidade “OCT-Angiography” (ou angiotomografia), que permite avaliar a circulação sanguínea da parte central da retina sem a necessidade de exame com contraste.
Normalmente é necessário dilatar as pupilas para fazer o exame com total qualidade e alguns pacientes quando dilatam as pupilas sentem piora da visão por algumas horas, geralmente não é recomendado dirigir depois do exame até a pupila voltar ao normal.
Exame normal de OCT da região da mácula:
OCT normal
Exame de OCT alterado mostrando edema cistóide:

Edema Cistoide no exame de OCT
Geralmente solicitamos exames nos laboratórios com os melhores aparelhos de São Paulo: Laboratório Fleury, Instituto da Visão e Retina Clinic. Os exames podem ser cobertos pelo convênio de saúde, dependendo do plano de cada paciente.
Atenção: Este exame não é realizado na Clínica Belfort.
Existem diversos centros diagnósticos onde este exame pode ser realizado, geralmente recomendamos o Instituto da Visão (IPEPO – tel 11 3016-4080) ou o Laboratório Fleury (tel 11 3179-0822).
Ambos aceitam convênio e particular, nenhum tem relação comercial com a Clínica Belfort, mas excelente qualidade nos exames e atendimento. Pode ser necessário relatório para que o exame seja coberto pelo plano de saúde.
A Clínica Belfort possui a solução mais completa para as doenças oculares. Além de tratamento com os melhores profissionais do país, a clínica conta com os mais diversos exames e cirurgias oftalmológicas.
Para agendar uma consulta com a nossa equipe, é só entrar em contato por e-mail ou ligar em um dos nossos telefones.
Veja mais:
Existe injeção no olho? Para que serve?
Doença relacionada:
Exame Relacionado: